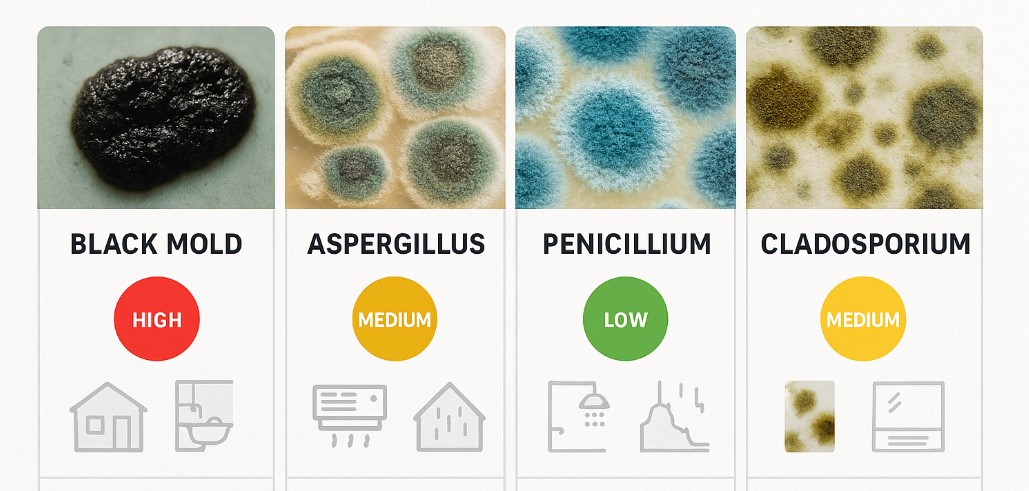
common household mold types identification chart showing black mold aspergillus penicillium and cladosporium

3 Best Mold Removal Companies in Ottawa
Finding the right mold removal company in Ottawa can protect your health and save thousands in property damage. This guide compares Ottawa’s top three certified mold remediation experts based on services, pricing, certifications, and customer satisfaction. Whether you need emergency black mold removal, eco-friendly treatments, or commercial remediation, we’ve ranked the best options for your specific needs.
π Quick Navigation

Why Does Choosing the Right Mold Company Matter?
Mold problems don’t wait. Every day you delay increases health risks and repair costs. Ottawa’s humid summers and cold winters create perfect conditions for mold growth in homes and businesses.
The right company stops mold fast and prevents it from coming back. The wrong choice can waste money, leave mold behind, and put your family at risk. This guide helps you pick the best company for your situation.

What Makes a Mold Company “Best” in Ottawa?
Proper Certifications
IICRC, AMRT, NAMP certified professionals ensure industry-standard work
Fast Response
Same-day or 24/7 emergency service when you need it most
Complete Solutions
Inspection, testing, removal, and prevention in one package
Clear Pricing
Transparent quotes and guarantees with no hidden fees
Understanding different types of mold helps you know what services you need. Some molds are more dangerous than others, and professional services handle all types safely.
Ottawa’s Top 3 Mold Removal Companies: Complete Comparison
Mold Busters Ottawa
Best for Experience & Comprehensive Services

Mold Busters brings 20+ years of Ottawa experience with over 17,000 inspections completed. Their track record speaks to their expertise and reliability in the local market.
π Why They’re #1
- 20+ Years Experience: Two decades solving Ottawa’s unique mold challenges
- 17,000+ Inspections: Massive service volume proves expertise
- BBB A+ Rating: Consistent quality and customer satisfaction
- Price Match Guarantee: Never overpay for quality service
- Advanced Technology: Thermal imaging finds hidden mold
β Pros
- Most experience in Ottawa market
- Comprehensive services beyond mold
- BBB accredited with A+ rating
- Thermographic inspections available
- Handles commercial and government properties
- Same-day inspections often available
β Cons
- Busy schedule shows customer trust and satisfaction
- Results-focused approach over trendy green marketing
π Phone: (877) 566-6653
π Website: bustmold.com/locations/ottawa
β° Hours: Customer service 24/7, Inspections 8 AM-5 PM
Mold Inspection Canada
Best for Customer Support & Eco-Friendly Solutions

Mold Inspection Canada serves both Ontario and Quebec with a customer-first approach and advanced technology. The company focuses on fast, professional service with strong environmental commitments.
π What Makes Them Stand Out
- Free Virtual Inspections: Professional assessment from home
- 24/7 Customer Support: Real people, any time
- Eco-Friendly Leader: Chemical-free, safe treatments
- Price Match Guarantee: Competitive pricing assured
- Wide Coverage: Serves Ontario and Quebec
β Pros
- Free virtual inspections save time
- 24/7 customer support availability
- Leading eco-friendly options
- Extensive Ontario & Quebec coverage
- Multiple industry certifications
- Strong customer education focus
β Cons
- Newer to Ottawa market (still highly qualified)
- Popular service means booking ahead recommended
- Focus on quality over volume
π Ontario: (613) 701-9893
π Quebec: (514) 700-6838
π Website: MoldInspection.ca
β° Hours: 24/7 customer support
Mold Remediation Service
Best for Virtual Inspections & Regional Coverage
Mold Remediation Service brings 19 years of experience serving Ottawa and Montreal. They focus on accessible service through free virtual inspections and eco-friendly solutions.
π Key Highlights
- Free Virtual Consultations: Fast, convenient assessments
- 19 Years Experience: Solid expertise across Ontario & Quebec
- Eco-Friendly Focus: Safe, responsible solutions
- Certified Team: Multiple industry certifications
- Technology-Forward: Modern assessment tools
β Pros
- Free virtual inspections available
- 19 years of industry experience
- Eco-friendly treatment options
- Serves Ottawa and Montreal
- Technology-forward approach
- Transparent pricing structure
β Cons
- Focused approach on residential solutions
- Ideal for typical home mold situations
- Building online reputation (stellar offline track record)
π Phone: (613) 707-7606
π§ Email: [email protected]
π Website: moldremediationservice.com
π Service: Ottawa & Montreal
π Side-by-Side Comparison: Which Company Wins for Your Needs?
| Feature | Mold Busters | Mold Inspection Canada | Mold Remediation Service |
|---|---|---|---|
| Experience | 20+ years | 15+ years | 19 years |
| Free Virtual Inspection | Yes | Yes | Yes |
| 24/7 Support | Yes | Yes | Business Hours |
| Price Match | Yes | Yes | No |
| Service Areas | Ottawa area | Ontario & Quebec | Ottawa & Montreal |
| BBB Accredited | A+ Rating | No | No |
| Eco-Friendly Focus | Full | Leading | Yes |
| Same-Day Service | Often | Often | Available |
| Overall Rating | 9.5/10 | 9.3/10 | 9.0/10 |
π‘ Quick Decision Guide
Choose Mold Busters if: You have large/complex projects, need thermography, or want BBB accreditation
Choose Mold Inspection Canada if: You want free virtual inspections, 24/7 support, or eco-friendly options
Choose Mold Remediation Service if: You prefer virtual-first consultations and competitive pricing in Ottawa/Montreal
Watch: Complete Guide to Choosing Ottawa’s Best Mold Removal Company
See our expert comparison and learn how to identify the right mold removal company for your specific needs in just 8 minutes.
ποΈ Residential vs. Commercial Mold Removal: What’s the Difference?

Mold removal needs vary greatly between homes and businesses. Understanding these differences helps you choose the right service approach.
How Home Mold Removal Works
Residential mold problems usually start small. A leaky pipe, poor ventilation, or basement moisture creates growth spots. Homeowners often discover mold in three common areas:
Basement Mold
Damp foundations and flooding cause basement mold. Learn how basement mold develops and what to do about it.
Attic Mold
Roof leaks and poor ventilation create attic mold. Attic mold problems often stay hidden for months.
Bathroom Mold
Showers and humidity make bathrooms mold havens. Bathroom and shower mold grow fast.
Home mold removal usually takes 1-3 days for small problems. Large infestations need a week or more. Costs typically range from $500 to $6,000 depending on size and severity.
Commercial Property Challenges
Business mold removal faces different challenges:
- Size and Scale: Commercial buildings have more square footage requiring specialized approaches
- Minimal Downtime: Businesses lose money when closed, requiring fast, efficient work
- Higher Stakes: Business mold inspection protocols follow stricter standards
- Regulatory Compliance: Must meet workplace safety regulations and documentation requirements
- Insurance Complexity: Commercial policies have different coverage rules
Average Cost Comparison
π¦ What Type of Mold Do You Have? Severity Levels Explained
Not all mold is the same. Different species cause different problems. Knowing your mold type helps you choose the right treatment approach.
Black Mold (Stachybotrys chartarum)
β οΈ High Risk – Always Requires Professional Removal
Black mold produces toxins that cause serious health problems. Health risks of black mold include respiratory issues, headaches, and immune system problems.
Where It Grows: Drywall, ceiling tiles, wood, paper, and dust. Needs constant moisture to thrive.
Health Impact: High risk. Can cause chronic coughing, fatigue, headaches, and respiratory infections.
Removal Needs: Always hire professionals. Black mold requires containment, protective gear, and proper disposal methods. Never try DIY black mold removal.
Common Household Molds
Aspergillus
Risk: Medium
Where: Food, AC systems, walls
Treatment: Professional for large areas
Penicillium
Risk: Medium
Where: Wallpaper, carpets, mattresses
Treatment: Professional for large growth
Cladosporium
Risk: Low-Medium
Where: Fabrics, wood, HVAC
Treatment: DIY for small patches
Identifying common household molds helps you understand what you’re dealing with.
Mold Severity Scale
DIY possible if caught early
Professional inspection recommended
Professional removal required
Extensive professional work needed
β‘ Emergency & Same-Day Services: When You Can’t Wait

Some situations can’t wait for a scheduled appointment. Emergency mold removal becomes necessary in specific cases.
π¨ When to Call for Emergency Service
- Family member with severe respiratory distress
- Recent flooding with visible mold starting
- Sewage backup contaminating living areas
- Black mold found in occupied areas
- Real estate closing requires mold clearance
- Insurance claim deadline approaching
How Emergency Services Work
First Contact (0-2 hours)
Real person answers. They assess situation urgency and gather key information about your mold problem.
Rapid Response (2-4 hours)
Certified technician arrives on-site. Quick assessment identifies immediate health risks and containment needs.
Immediate Action (4-8 hours)
Team starts emergency containment. Set up barriers, run HEPA filtration, stop water sources, make area safe.
Follow-Up Plan (Next Day)
Complete remediation scheduled. Full inspection, detailed plan, cost estimate, timeline, and insurance coordination.
π° Emergency Service Costs
Emergency and same-day services typically cost 20-50% more than scheduled appointments. The premium covers after-hours availability, rapid mobilization, and immediate equipment deployment. Most companies waive or reduce fees if you proceed with full remediation.
Company Emergency Availability
- Mold Busters: 24/7 customer service, emergency situations get priority response
- Mold Inspection Canada: 24/7 support, same-day virtual inspections always available
- Mold Remediation Service: Business hours support, virtual consultations available same-day
πΏ Eco-Friendly & Chemical-Free Mold Treatments
Traditional mold removal uses harsh chemicals. These products kill mold but leave residues that affect health. Eco-friendly treatments work just as well without the risks.
Why Choose Green Mold Removal?
Safe for Children
No toxic fumes or lingering odors. Kids can return home immediately after treatment.
Pet-Friendly
Won’t harm dogs, cats, birds, or other pets during or after application.
Allergy-Safe
Better for people with asthma, allergies, or chemical sensitivities.
Environmental
Responsible disposal and no VOC emissions protect the planet.
Chemical-Free Mold Removal Methods
- Dry Ice Blasting: Uses compressed CO2 pellets. Kills mold through extreme cold without moisture or chemicals.
- HEPA Vacuuming: Captures 99.97% of particles. Removes mold spores from air and surfaces without chemicals.
- UV-C Light Treatment: Ultraviolet light kills mold at DNA level. No chemicals required, prevents regrowth.
- Natural Antimicrobials: Plant-based products like tea tree oil and grapefruit seed extract fight mold naturally.
Which Companies Offer Green Options?
π₯ Mold Inspection Canada: Leads in eco-friendly treatments. Multiple chemical-free options as standard practice.
π₯ Mold Remediation Service: Emphasizes safe, eco-friendly solutions. Environmental responsibility is core value.
π₯ Mold Busters: Provides low-toxicity options on request. Less emphasis than competitors but available.
Choosing safe remediation services means considering both effectiveness and safety.
π Certifications & Licenses: Why They Matter

The Institute of Inspection, Cleaning and Restoration Certification (IICRC) sets industry standards. IICRC certification proves a company follows best practices.
Key Industry Certifications
IICRC Certified
Global gold standard. Requires classroom training, hands-on experience, and continuing education.
AMRT Certification
Applied Microbial Restoration Technician. Advanced mold training in microbiology and contamination control.
NAMP Certified
National Association of Mold Professionals. Specialized focus on mold inspection and remediation.
NORMI Certified
Independent training in indoor air quality, building sciences, and environmental hazards.
All Three Companies Hold Multiple Certifications
- Mold Busters: NAMP, IICRC, Certified Thermographers, BBB Accredited
- Mold Inspection Canada: NORMI, InterNACHI, IICRC, CRMI, NAMP
- Mold Remediation Service: IICRC, NAMP, InterNACHI, NORMI, NAMRI, CMI
π© Red Flags: Avoid Uncertified Companies
Never hire companies that can’t provide certification numbers, offer prices 30%+ below certified competitors, rush you to sign contracts, use scare tactics, or operate without insurance verification. Mold allergies and symptoms get worse with improper removal.
π° Understanding Mold Removal Costs in Ottawa

Mold removal costs vary widely based on several factors. Understanding these helps you budget accurately.
What Affects Your Price?
Project Size
Square footage is biggest cost factor. Under 10 sq ft: $500-$1,500. Over 100 sq ft: $7,000-$15,000+
Mold Location
Easy access (walls, basements) costs less. Hidden areas (inside walls, under floors) cost more.
Mold Type
Standard mold is cheaper. Black mold requires extensive containment and protective measures.
Structural Damage
Material replacement adds cost. Drywall, wood framing, flooring, insulation replacement required.
Mold removal costs depend on accurate measurement. Companies charge by contaminated area, not room size.
Average Ottawa Price Ranges (2025)
Inspection Costs
Insurance Coverage
π When Insurance Usually Covers Mold
- Mold from sudden pipe burst
- Growth from covered water damage
- Mold after sewage backup (with rider)
- Fire-related mold development
β When Insurance Usually Doesn’t Cover
- Mold from poor maintenance
- Long-term leak ignored
- Humidity and condensation issues
- Cosmetic mold on surfaces
All three top companies work with insurance companies. They provide detailed documentation and communicate with adjusters.
Price Match Guarantees
Mold Busters and Mold Inspection Canada both offer price matching. Show a written quote from a certified competitor with comparable scope, and they’ll match or beat the price. This removes price-shopping stress while ensuring quality work.
π Frequently Asked Questions
Professional help is needed when:
- Mold covers more than 10 square feet
- You smell mold but can’t find it
- Mold keeps coming back after cleaning
- Someone in your home has health symptoms
- You find black mold (Stachybotrys)
- Mold is in HVAC system
- You have water damage
DIY mold testing versus professional inspection helps you decide. Small surface mold might be DIY. Hidden or extensive growth needs experts.
Timeline depends on project size:
- Small area (under 10 sq ft): 1-2 days
- Medium project (10-30 sq ft): 2-4 days
- Large remediation (30-100 sq ft): 4-7 days
- Extensive work (over 100 sq ft): 1-3 weeks
Add time for testing, lab results, material ordering, clearance testing, and repairs.
Small projects allow you to stay home. Large projects require temporary relocation.
You Can Stay If: Mold is in unused area, proper containment is set up, no one has severe allergies, work area is isolated, good ventilation prevents spread.
You Should Leave If: Mold covers multiple rooms, black mold is being removed, someone is immunocompromised, containment can’t prevent spore spread, or strong odors affect living areas.
Mold Removal: Removes visible mold, cleans surfaces, quick fix approach, may not prevent return.
Mold Remediation: Removes visible mold, kills mold spores, fixes moisture source, prevents future growth, more comprehensive, better long-term solution.
Professional companies do remediation, not just removal. Professional versus DIY mold removal explains why this matters.
- Free virtual inspection: $0 (Mold Inspection Canada and Mold Remediation Service offer this)
- Basic visual inspection: $200-$400
- Inspection with air testing: $400-$800
- Comprehensive inspection: $600-$1,200
Many companies credit inspection fees toward remediation if you hire them.
Black mold (Stachybotrys) produces mycotoxins that cause health problems. Not all black-colored mold is Stachybotrys, but confirmed black mold risks include:
- Respiratory issues
- Chronic fatigue
- Headaches
- Skin irritation
- Immune system suppression
Children, elderly, those with asthma/allergies, immunocompromised individuals, and pregnant women are most at risk. Never try DIY black mold removal. Health risks of black mold exposure are too serious.
Short-Term Steps: Fix all leaks immediately, use bathroom exhaust fans, run dehumidifiers in damp areas, wipe up spills, open windows for ventilation.
Long-Term Solutions: Install proper gutters and downspouts, fix foundation drainage, improve home ventilation, use mold-resistant materials, monitor humidity levels (keep below 50%).
All three top companies provide prevention guidance and identify moisture sources.
Yes. Landlords must maintain safe living conditions. Mold inspection for renters has specific considerations.
Steps for Renters:
- Document the mold with photos
- Notify landlord in writing
- Request professional inspection
- Follow up if no action taken
- Contact housing authority if needed
Landlord pays if mold from building issues. Tenant may pay if mold from their negligence.
π Ready to Solve Your Mold Problem?
Don’t waitβmold gets worse every day. All three companies respond quickly and provide professional, certified service.
Take Action Today:
- Call Mold Busters: (877) 566-6653 for experienced, comprehensive service
- Call Mold Inspection Canada: (613) 701-9893 for free virtual inspection & eco-friendly options
- Call Mold Remediation Service: (613) 707-7606 for virtual-first consultations
Signs of mold in homes help you spot problems early. Early detection means easier, cheaper removal.
